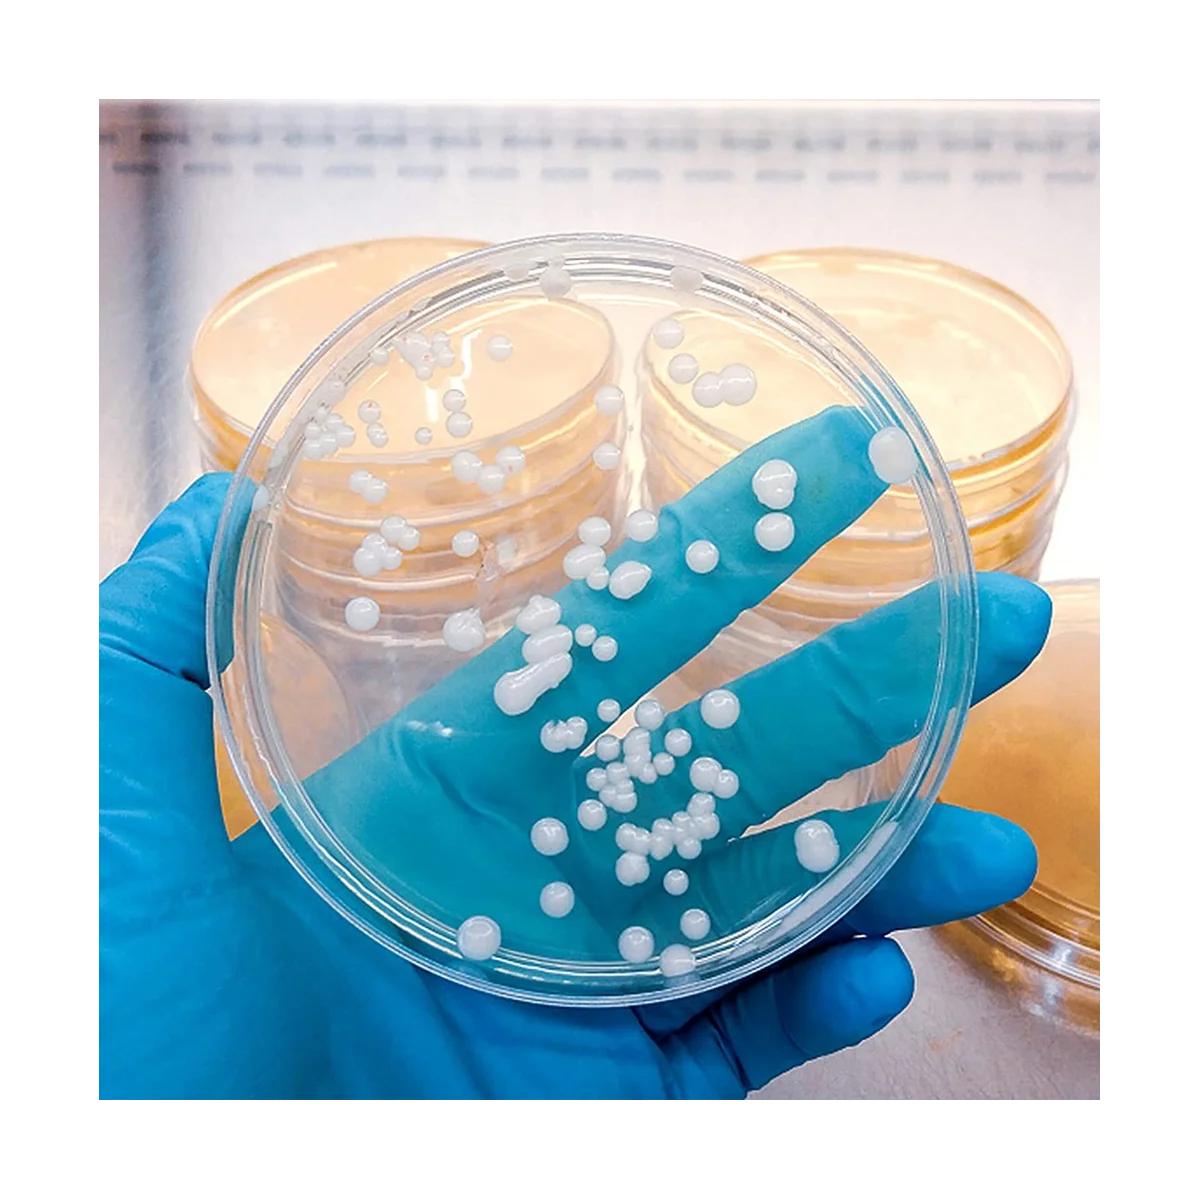

80 шт./упаковка, пластиковые чаши Петри 90 мм с крышками
График изменения цены & курс обмена валют
Пользователи также просматривали

$10.18
Splicing Red Handkerchief Jeans High Street Straight Leg Fashion Y2K American Oversized Women's Loose Bent Knife Pants New
aliexpress.ru
$10.69
раздвижные варежки раздвижные варежки для бейсбола раздвижные бейсбольные перчатки раздвижные перчатки бейсбольные спортивные перчатки бейсбольные перчатки
aliexpress.ru
$21.30
2024 New Women's Yoga Top Defin Gold Zipper Outdoor Sport Stand Collar Jacket Fashionable No Net Fabric Outdoor Wear
aliexpress.com
$12.38
Nast Hyde Halt Logo T-Shirt Funny t-shirts basketball graphic tees shirts graphic clothing for men
aliexpress.com
$1,667.05
Turbo Kits for Suba*ru 2012+ BRZ FR-S GT 86 FA20 GT28 Charger Manifold AC Retain
aliexpress.com
$834.30
UK Warehouse Free Delivery Rechargeable Ebike Rear Rack Battery 48V18Ah E-Bike Lithium Ion Battery Pack for Bicycle 48v 1000w
aliexpress.com
$5.43
Y2k Sleeveless Orange Midi Women's Dresses Side Slit Turtleneck Setting Bodycon Sexy Party Elegant Dress 2025 Basic Vintage Robe
aliexpress.com
$51.58
Для Mercedes-AMG GT, carbon fiber ABSV class, gla glbces paddle shifter, E-class, CLS Maybach C-class
aliexpress.com
$2.98
1Pc Weightlifting Bandage Bracers Elastic Breathable Gym Fitness Powerlifting Wrist Support Non-Slip Comfortable Wristband
aliexpress.com
$0.97
10pcs 5W Carbon Film Resistor 5% 4R7 47R 470R 4K7 47K 470K 4.7 47 470 R K Ohm 1R-1M
aliexpress.com
$8.05
2023 Summer Women Abstract Sleeveless V-Neck Casual Halter Tank Top Female Tee Cami Wrap Tops y2k Woman Streetwear Clothes
aliexpress.com
$29.36
Передняя левая прозрачная накладка на переднюю фару автомобиля, сменная накладка на переднюю фару головного света, оболочка для Audi A4 B8
aliexpress.com
$1.14
1pc Colour LED Bulb E27 220V G45 7 Color RGB Lampada LED Lamp Decor Holiday Christmas Lamparas Light Bulb Fashlight
aliexpress.com
$1.69
Змеиная приманка 10 г или 15 г, металлическая приманка, 2 цвета, металлическая рыболовная приманка
aliexpress.ru
$33.45
Новая автоматическая Топливная форсунка с автоматическим отключением Топливная форсунка Автомобильная Топливная форсунка 3/4 дюйма NPT с высоким потоком подходит для различных бензинов
aliexpress.ru
$12.56
Board Dry Erase Lightled Message Whiteboard Memo Cloud Writing Reusable Menu Acrylic Decoration Note Desktop Night Lamp White
aliexpress.com
$35.06
Женская куртка из искусственной овечьей шерсти, с ворсом, однобортная, теплая, без рукавов, на осень и зиму, A599, 2021
aliexpress.ru
$13.26
Replacements Main Brush Side Brush Hepa Filter Mop Cloth For Xiaomi Roborock S7 T7S T7S PLUS Vacuum Cleaner Spare Parts
aliexpress.com
$11.48
100 шт. одноразовые стаканы для выпечки из алюминиевой фольги, форма для яичницы, кастрюли, капкейка, чехла, смолы, торта
aliexpress.ru
$14.20
Bikini 2022 Woman Vintage Print Sexy Bikini Ladies Split Swimsuit New Fashion Bikini Girl Summer Swimwear Women L
aliexpress.com
$21.00
YOUPIN xiaoxiaotu против зуда коробка Портативный Смарт Контроль температуры противозудный инфракрасный импульсный уменьшает отеки для облегчени...
aliexpress.ru
$0.88
2020 Computer PC Fan 80mm With LED 8025 Silent Cooling Fan 12V LED Luminous Chass Computer Case Cooling Fan Mod Easy Installed
aliexpress.com
$14.25
Rack Sponge Holder Detachable Faucet Home Kitchen Sink Caddy Bathroom Dish Cloth Drain Storage Drying Adjustable Strap Hanging
aliexpress.com
$2.19
Men's Vintage Titanium Steel Wolf Head Cool Punk Bangle Bracelet Braided Leather Wristband Jewelry
buyincoins.com
$645.85
Стол обеденный раскладной в гостиную, кухню Elvi Black Marble керамика/металл черный Concepto
rozetka.com.ua
$8.49
320Pcs Carbon Steel Compression Type Wavy Wave Crinkle Spring Three Wave Washers Assortment Kit
aliexpress.com
$117.00
Full Coverage Eco-leather auto seats covers PU Leather Car Seat Covers for i40 hyundai genesis equus creta ix25 tucson ix35
aliexpress.com
$50.77
LOUIS YAO Exquisite Women's Cardigan Jacket 2025 Autumn Color Contrasting Ribbon Splicing Baseball Shirt Embroidered Zipper Coat
aliexpress.com
$7.70
15 Pcs Carpet Stair Mats Rug Stairs Runner Polyester (Polyester) Treads for Carpeted along with
aliexpress.com